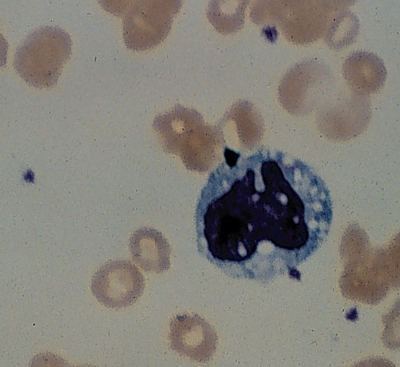

Online responses are no longer available. Please refer to our instructions for authors page for more information.
Connect
Advertisement
Australia antigen
Med J Aust 2002; 177 (11): 680. || doi: 10.5694/j.1326-5377.2002.tb05016.x
Published online: 9 December 2002
Published online: 9 December 2002
Advertisement

Thanks to Mr J A Manitta, Senior Haematologist, Malaria Reference Laboratory, Clinical Pathology Department, Fairfield Hospital (now the Victorian Infectious Diseases Reference Laboratory).